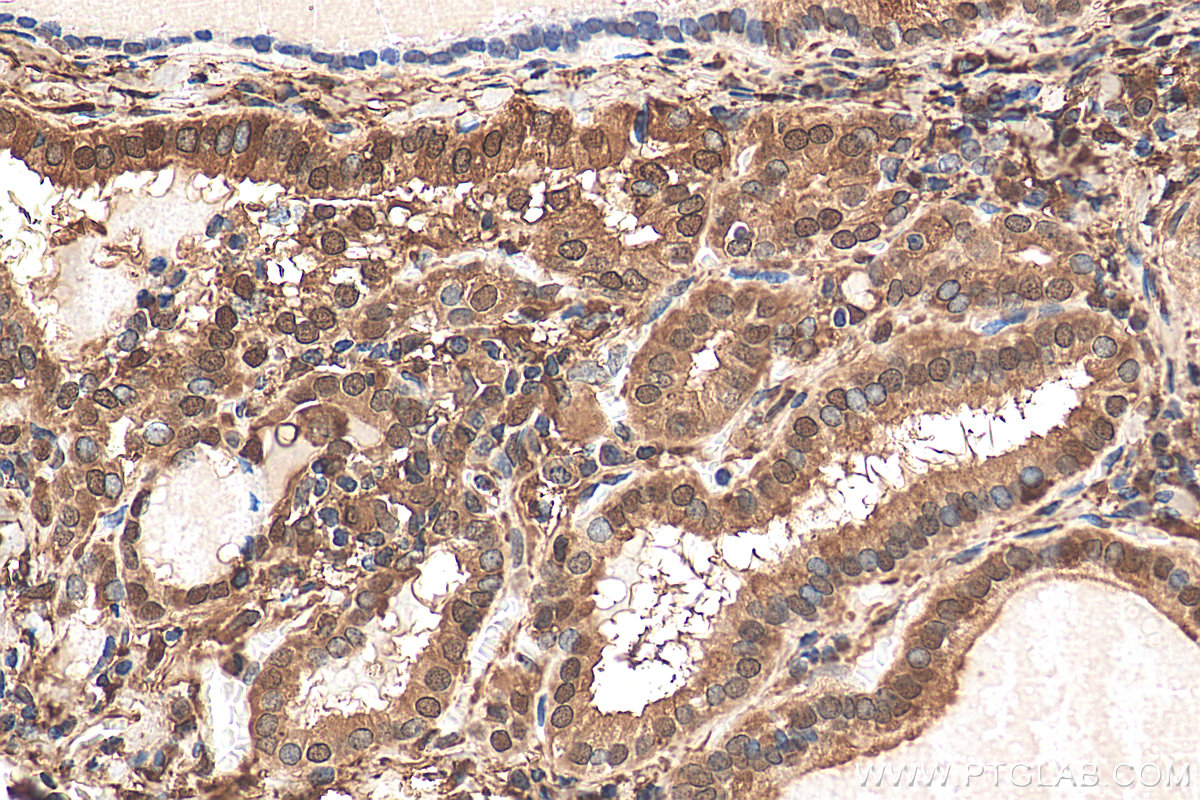

验证数据展示
经过测试的应用
| Positive WB detected in | HeLa cells, human heart tissue, rat colon tissue, MCF-7 cells, NIH/3T3 cells |
| Positive IP detected in | MCF-7 cells |
| Positive IHC detected in | human thyroid cancer tissue, human colon tissue Note: suggested antigen retrieval with TE buffer pH 9.0; (*) Alternatively, antigen retrieval may be performed with citrate buffer pH 6.0 |
| Positive IF/ICC detected in | HeLa cells |
| Positive FC (Intra) detected in | HeLa cells |
推荐稀释比
| 应用 | 推荐稀释比 |
|---|---|
| Western Blot (WB) | WB : 1:5000-1:50000 |
| Immunoprecipitation (IP) | IP : 0.5-4.0 ug for 1.0-3.0 mg of total protein lysate |
| Immunohistochemistry (IHC) | IHC : 1:50-1:500 |
| Immunofluorescence (IF)/ICC | IF/ICC : 1:50-1:500 |
| Flow Cytometry (FC) (INTRA) | FC (INTRA) : 0.40 ug per 10^6 cells in a 100 µl suspension |
| It is recommended that this reagent should be titrated in each testing system to obtain optimal results. | |
| Sample-dependent, Check data in validation data gallery. | |
产品信息
14979-1-AP targets Galectin-3 in WB, IHC, IF/ICC, FC (Intra), IP, ELISA applications and shows reactivity with human, mouse, rat samples.
| 经测试应用 | WB, IHC, IF/ICC, FC (Intra), IP, ELISA Application Description |
| 文献引用应用 | WB, IHC, IF, IP |
| 经测试反应性 | human, mouse, rat |
| 文献引用反应性 | human, mouse, rat, pig |
| 免疫原 |
CatNo: Ag6891 Product name: Recombinant human Galectin 3 protein Source: e coli.-derived, PGEX-4T Tag: GST Domain: 1-250 aa of BC001120 Sequence: MADNFSLHDALSGSGNPNPQGWPGAWGNQPAGAGGYPGASYPGAYPGQAPPGAYPGQAPPGAYPGAPGAYPGAPAPGVYPGPPSGPGAYPSSGQPSATGAYPATGPYGAPAGPLIVPYNLPLPGGVVPRMLITILGTVKPNANRIALDFQRGNDVAFHFNPRFNENNRRVIVCNTKLDNNWGREERQSVFPFESGKPFKIQVLVEPDHFKVAVNDAHLLQYNHRVKKLNEISKLGISGDIDLTSASYTMI 种属同源性预测 |
| 宿主/亚型 | Rabbit / IgG |
| 抗体类别 | Polyclonal |
| 产品类型 | Antibody |
| 全称 | lectin, galactoside-binding, soluble, 3 |
| 别名 | 35 kDa lectin, Carbohydrate-binding protein 35, CBP 35, CBP35, Gal 3 |
| 计算分子量 | 26 kDa |
| 观测分子量 | 31 kDa |
| GenBank蛋白编号 | BC001120 |
| 基因名称 | Galectin-3 |
| Gene ID (NCBI) | 3958 |
| RRID | AB_2136768 |
| 偶联类型 | Unconjugated |
| 形式 | Liquid |
| 纯化方式 | Antigen affinity purification |
| UNIPROT ID | P17931 |
| 储存缓冲液 | PBS with 0.02% sodium azide and 50% glycerol, pH 7.3. |
| 储存条件 | Store at -20°C. Stable for one year after shipment. Aliquoting is unnecessary for -20oC storage. |
背景介绍
Galectins are a family of animal lectins defined by shared characteristic amino-acid sequences and affinity for β-galactose-containing oligosac-charides (PMID: 8063692). Galectin-3, a member of the β-galactoside-binding proteins, contains one carbohydrate recognition domain (CRD) and a proline- and glycine-rich N-terminal domain through which is able to form oligomers (PMID: 14758078). Galectin-3 is widely expressed in many normal tissues and a variety of tumors. It is found intracellularly in nucleus and cytoplasm or secreted outside of cell, being present on the cell surface or in the extracellular space (PMID: 16478649). Galectin-3 is involved in various biological processes including cell growth, adhesion, differentiation, apoptosis, angiogenesis, immune response, neoplastic transformation and metastasis (PMID: 16478649; 14758078).
实验方案
| Product Specific Protocols | |
|---|---|
| FC protocol for Galectin-3 antibody 14979-1-AP | Download protocol |
| IF protocol for Galectin-3 antibody 14979-1-AP | Download protocol |
| IHC protocol for Galectin-3 antibody 14979-1-AP | Download protocol |
| IP protocol for Galectin-3 antibody 14979-1-AP | Download protocol |
| WB protocol for Galectin-3 antibody 14979-1-AP | Download protocol |
| Standard Protocols | |
|---|---|
| Click here to view our Standard Protocols |
发表文章
| Species | Application | Title |
|---|---|---|
Nat Immunol Heme drives hemolysis-induced susceptibility to infection via disruption of phagocyte functions. | ||
Redox Biol Cathepsin C from extracellular histone-induced M1 alveolar macrophages promotes NETosis during lung ischemia-reperfusion injury | ||
Br J Pharmacol Substitution of the SERCA2 Cys(674) reactive thiol accelerates atherosclerosis by inducing endoplasmic reticulum stress and inflammation | ||
J Neuroinflammation Progranulin haploinsufficiency mediates cytoplasmic TDP-43 aggregation with lysosomal abnormalities in human microglia | ||
Acta Pharmacol Sin Modified citrus pectin inhibits breast cancer development in mice by targeting tumor-associated macrophage survival and polarization in hypoxic microenvironment |